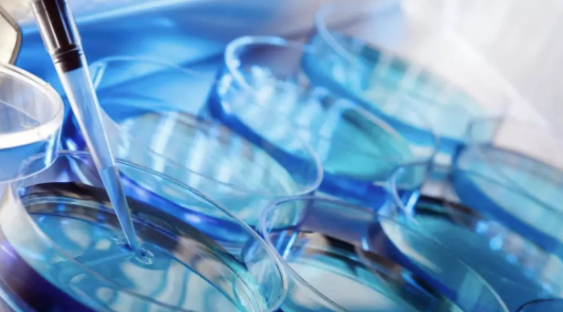

近几年,澳大利亚也渐渐成为众多准妈妈们的产子圣地。是什么驱使越来越多的中国孕妈不远万里,从北半球到南半球赴澳产子?赴澳产子背后又蕴藏着哪些商机?
前言
还记得电影《北京遇上西雅图》吗?汤唯饰演小三文佳佳,男友是个大款。她为了生下孩子,不会英语,怀揣一张无上限的信用卡远赴美国,来到西雅图的华人月子中心待产生子,而她与吴秀波饰演的司机也渐渐滋生出爱情。虽然影片某些情节有些狗血,但是“赴美生子”这一话题却在影迷间迅速发酵。

在美国,早已悄悄地出现了一大批华人“月子中心”,很多孕妇不惜远途奔波,特意挺着个大肚子去国外生孩子。
近几年,澳大利亚也渐渐成为众多准妈妈们的产子圣地。是什么驱使越来越多的中国孕妈不远万里,从北半球到南半球赴澳产子?赴澳产子背后又蕴藏着哪些商机?
阅读导航
一、中国人赴澳产子成为新潮流

目前,海外的准妈妈们赴澳产子已经成为新趋势。
数据显示,在过去的12个月里,大约有2500名没有医保的妈妈们在新州医院分娩,其中八分之一来自中国。新州卫生部门表示,尽管澳大利亚与包括英国、比利时、意大利和新西兰在内的11个国家,签订了互惠的免费医疗协议,但海外游客没有资格享受免费的公立医院治疗。
在公立医院里,非澳公民分娩住院的费用是非常高的,三天费用约为5200澳元,如果是私立医院,全额医疗费用可高达1.5-2万澳元,但这并没有阻挡住海外孕妇赴澳生产的步伐。
在Crows Nest,新州领先的产科医院之一玛特医院(Mater Hospital)也接待了一些来自中国的孕妈。医院为迎合市场,还提供普通话服务,同时推出了一条龙的普通话产前班和育儿课堂,一切只为了吸引中国顾客。
二、中国人赴澳产子的原因
近几年,中国结婚率持续走低。与5年前结婚人数高位(428.2万)相比,2018年一季度已经下降了29.54%。专家认为,适婚人口数量下降、婚龄推迟、城市化进程加快都是结婚人数不断下降的原因。
伴随着结婚率走低,中国社会诞生出一个新族群“优质大龄剩女”。这些女性大多精明能干,工资高且生活无忧,但却存在一个普遍问题:找不到男朋友。于是她们中的一些人萌生出一个新想法,依靠人工受精(IVF)做个单亲妈妈不就行吗?
人工受精(IVF)即人工受孕,即为将男性精液用人工方法注入女性子宫颈或宫腔内,以协助受孕的方法,在中国,主要用于不孕症。
其实IVF在国内已经相当普遍,但在国内做IVF,必须得身份证、结婚证、准生证三证齐全。如果您是单身,是不允许做IVF的。 所以,在中国,人工授精只适合于不孕不育的夫妇,且证件齐全才行。但是对于那些渴望生育的未婚女性,她们是没有权利接受精子捐赠的,更何况做人工受精的人太多,想排队最多也要等上数月,甚至2年。
所以,一小部分独立的中国女性为了成全自己为人母的心,纷纷赴澳产子。
澳大利亚媒体SBS曾报道,30岁出头、仍然单身的陈晃(音译),在父母的陪伴下,来到澳洲做人工受精(IVF),实现了想成为母亲的心愿。陈晃说:” 因为没有结过婚,在决定做之前,我和家人整整纠结了一年。思考了很多问题:比如孩子出生后,我该怎么告诉朋友和家人?我应该公开吗?当孩子长大后,我该怎么跟他们说?”
未婚赴澳生子的话题,也一度引起广泛的社会争论。有人认为,一个女人渴望生宝宝,让母性得到完整有错吗?应该尊重每个人的选择,她也是伟大的母亲。并呼吁中国开放单身女性生育政策,如果可以在国内选到优秀基因精子,并且能合法给孩子上户口就更好了。
也有人认为,这是一种不负责任,自私的表现。只有父母双全才能给孩子一个健康的家庭成长环境。那些认同“父亲”这种角色可有可无的“丧偶式”教育,根本没有站在孩子的立场考虑问题。一个女人在成全自己心愿的时候,是不是也该为孩子多想一想。
2. 给不孕不育人群多一个选择
当然,赴澳做IVF产子的也不全是未婚妈妈,也有很多年轻华人夫妇。IVF专家Andrew Kan,现在赴澳做IVF的中国人变多了,几乎每个月都要接待1-2名中国人。
那么,为什么一些中国夫妇不选择在中国做IVF,而要远赴澳洲?
首先,在中国,等待期更长。
虽然中国IVF市场需求很大,但中国只有约400个获得许可证的试管婴儿诊所,等待期少则数月,长得可达2年。从2013年开始,国家慢慢放开二胎政策,据估计在中国约有9000万妇女有资格生二孩,但到目前只增加了100万人口。主要因为在这9000万妇女中,年龄在40岁或以上的女性约50%,这群人已经错过了生育黄金年龄。
而在适龄生育的夫妇中,不孕症的发生率大概在10%-15%,也就是说每7到8对夫妇中就有1对不能正常怀孕。
据统计,每年新生儿约1600万,有约200-240万因为不孕不育无法出生,相较于辅助生殖每年70万例,供需缺口依然巨大。

其次,从成功率角度来看。
不考虑年龄因素,中国IVF的成功率一般在20%-30%左右。而在澳洲,澳洲医学杂志公布了一项研究称,有33%的女性第一次接受IVF,就能成功地怀孕并生出宝宝。就算第一次失败了,只要IVF进行到第八个周期,成功率就会猛增到54%-77%。对于有需求的人来说,这是一次相当值得的尝试。
而且,澳洲的IVF技术从某种程度上说比中国更成熟,临床期更久。1980年,全球第三个试管婴儿就诞生在澳洲。每年在澳洲出生的25个婴儿中,就有1个是通过人工授精得来的。
第三,在中国,对卵子或精子捐献、性别选择和冻胚胎等都有一定法律限制,部分原因是政府担忧闸门一旦打开,可能引发人口大爆炸和道德风险问题。所以,一些中国人会奔赴澳洲、美国、东南亚等地尝试生育。
最后,对比费用。
在中国,通常IVF花费约5000到3万元人民币不等,但除去全额医疗费用,加上机票、吃住和汇率比,在国外生孩子可能是中国的几倍,但许多中国人认为他们可以找到更高质量的护理和更高成功率。

目前,IVF技术已经发展到第三代,主要用于优选优生优育。对于一个中国家庭来说,如果可以通过IVF筛查最优质的胚胎生育,避免遗传缺陷。花再多钱他们认为也值得。
3. 为了身份 盲目赴澳产子
电影《北京遇上西雅图》里的文佳佳,不惜一切跑到美国去生孩子,就是为了给孩子一个美国国籍。一些中国孕妈认为,“只要去国外生孩子,就可以拿到外国国籍”,真的是这样的吗?笔者只能让说这些妈妈们过于天真,不了解政策就急于发动,那么,如果在澳洲生孩子,孩子就一定是澳洲国籍吗?
情况一:父母持有临时签证
如果父母双方或一方为澳临时居民,无人为澳永居或公民,他们的新生儿出生在澳洲境内,在出生那一刻,孩子将自动获得与父母相同,或与父或母一方相同的临时签证,签证条款也与父母或父或母一方相同。
情况二:父母一方持有永居权或澳籍
如父母双方有一方是澳大利亚永居居民或者是澳洲公民,且孩子在澳洲出生,那么孩子生下来就是澳洲公民。
情况三:父母双方为中国公民
在澳出生的新生儿的父母双方为中国公民,且儿童出生时父母均未获得澳永久居留权,则该儿童为中国国籍,可为其申请中国护照/旅行证。
因此,孩子出生在澳大利亚,不一定就会自动成为“外国人”。这一切完全取决于孩子父母的身份情况。也就是说,在美国生子仅是属地主义,然而在澳洲生子是血统主义和属地主义的结合。
三、 赴澳生子会面临哪些障碍

虽说澳洲的医疗水平、设备、服务都高于国内,但在澳洲生宝宝同样也存在着让人顾虑的地方。
1、在澳洲,分娩费用昂贵
世界知名医学期刊《柳叶刀》(The Lancet)最新调查数据显示,没有Medicare的情况下,澳大利亚妇女分娩是全球费用第二高的国家,仅比美国费用低。
一项调查显示14个发达国家中,结果显示,在澳洲剖腹产的医疗费用约为1.4万澳元,自然生产的医疗费用约为9089澳元。而在美国剖腹产约为1.51万澳元,自然生产的医疗费用则为1.37万澳元。
由于澳洲采取了很多措施降低产妇和新生婴儿的死亡率,产妇的医疗护理工作增加,所以导致生产费用高昂。如果产妇或婴儿出现并发症,费用还会更高。

2、语言障碍
如果英语不够好,在候诊和医生沟通的时候,一些专业术语可能把很多准爸准妈难住,比如妊娠期糖尿病症、麻醉、超声波、刨腹产、羊水等这些平时不常用的英语单词,即使雅思7.0,一听也懵圈了。所以,一些中国人赴澳产子只能找华人医生,可选择范围一下子缩小了。
过去2年来,随着中国人赴澳产子人数上升,澳洲诊所正在招聘会说普通话的医生和护士,以迎合市场需求。
3、孕期习惯不同
由于截然不同的中西方文化和人种体制的差异。90%的澳洲妇女不注重月子调养,而中国人是非常重视坐月子的,生产之后,产妇们被要求不能洗澡、洗头,不能吹风、出门等等,这对澳洲人来说是不可思议的。所以,在澳洲,没有月子中心,想要产后在澳洲坐月子的,必须得带上爸妈或国内月嫂一起。
四、澳洲生殖产业链酝酿新商机
在澳大利亚,一个新的生殖产业链正在形成。澳中国际医疗旅游服务中心(AC International Medical Tourism)与莫纳什IVF机构(Monash IVF Group)已经签署协议,计划开设中国患者赴澳接受生育治疗。
莫什IVF机构预计,在第一年将接待约100名中国夫妇赴澳怀孕产子。
Monash IVF集团首席执行官James Thiedeman表示,澳洲更人性化的病人护理,加上国际领先的成功率,使澳洲成为继美国之后,中国人产子最佳选择地之一。
一般,人工受孕的成功率取决于妈妈的年龄,如果妈妈三十五岁,试管婴儿成功率约是70%,人工受孕则只有10%到12%,如果妈妈已经四十岁,人工授精的成功率更低,小于5%,而试管婴儿的成功率也只剩55%左右。
所以,对一些高龄产妇来说,时间不等人。James Thiedeman认为,在中国,高龄不孕衍生出的生育需求,将帮助澳洲打开中国市场。

END
随着二胎政策放开,中国人也面临着一个尴尬局面,一类人不想要孩子,一类人想生孩子但已过了生育年龄,还有一些不能生育的年轻人,排队治疗要孩子。所以,大多数中国人选择到海外生孩子的原因:一是因为气候宜人,生育环境好。二是因为声誉好,医疗技术全球领先。
但其实出国生孩子,没有的想象那么简单!请所有计划去海外产子的孕妈们考虑一下:为什么要到国外生孩子?各国对于海外产子的政策如何?是否有月子会所,是否合法?孩子是否可以取得双重国籍?持外国国籍的孩子在国内如何上学?等了解完这些问题后,我想你的心里可能会有另一个答案。
资料参考:《2017年中国试管婴儿(IVF)行业专题研究报告》、SBS、The Australian